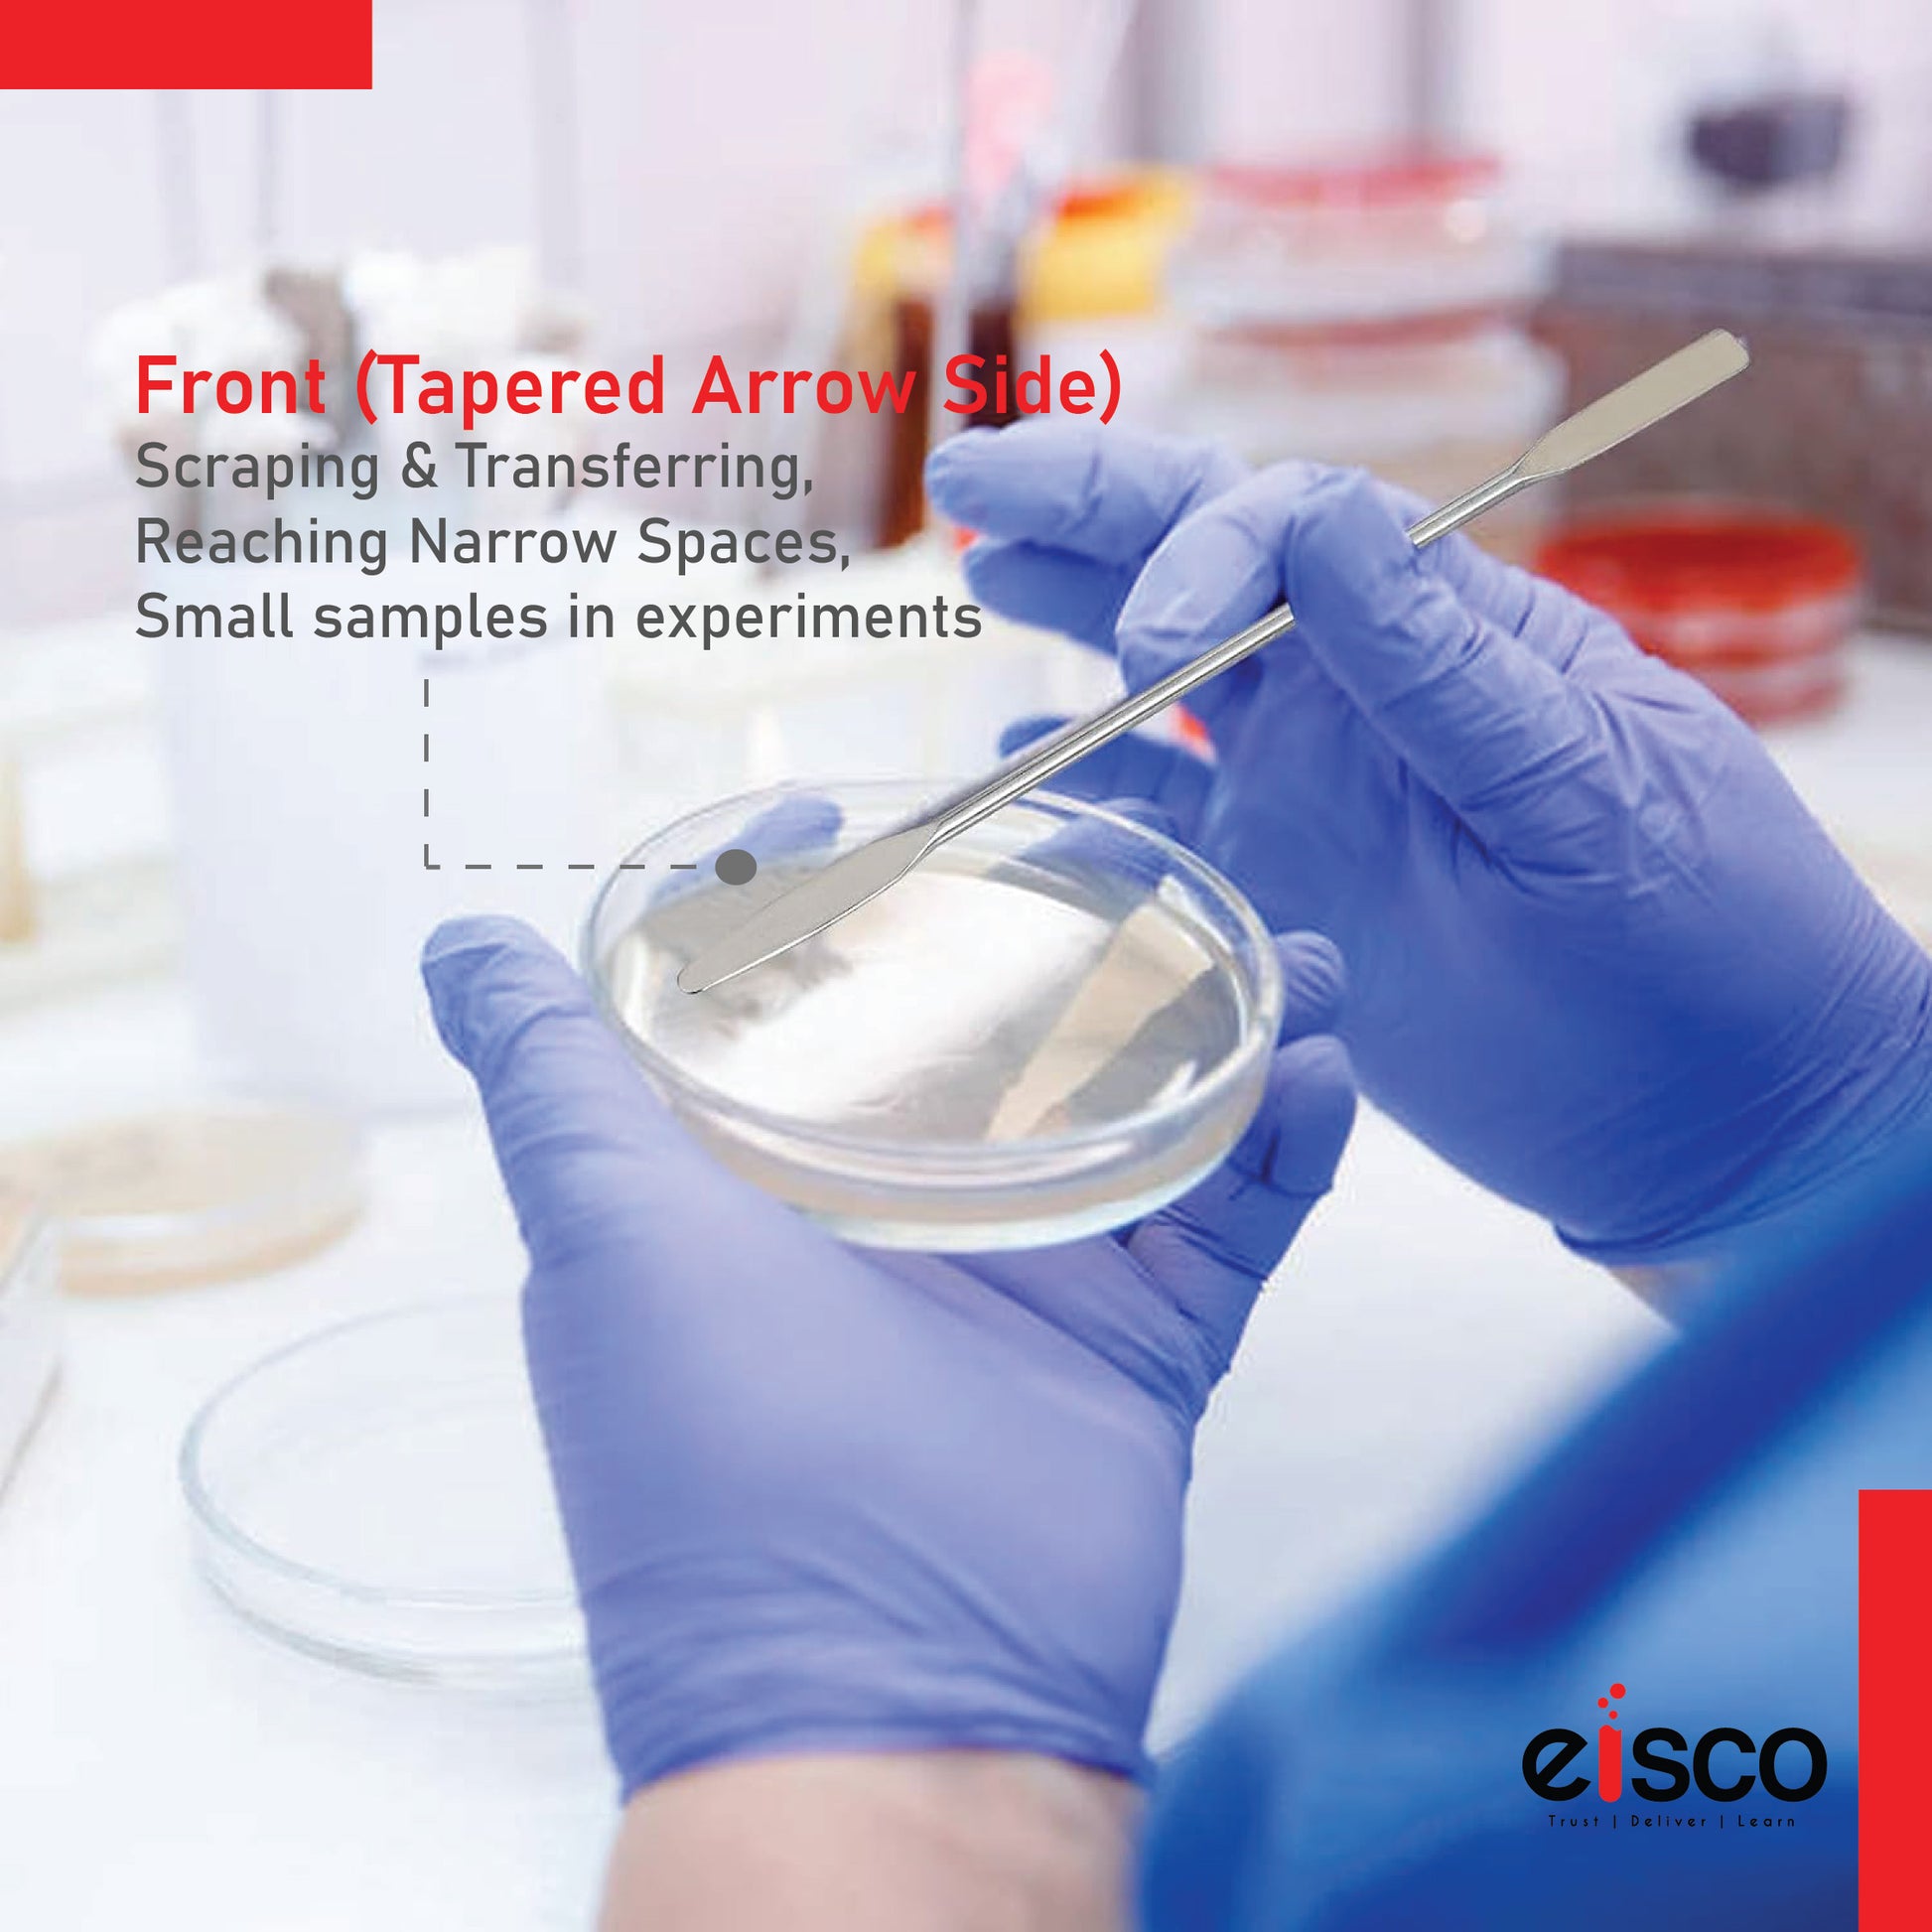

1
/
of
9
Eisco
EISCO Semi-Micro Spatula Double Bladed One End Rounded and Other End Tapered Stainless Steel Length - 20 cm Pack of 5
EISCO Semi-Micro Spatula Double Bladed One End Rounded and Other End Tapered Stainless Steel Length - 20 cm Pack of 5
SKU:CH0635E/PK5
Regular price
Rs. 589.00
Regular price
Rs. 703.00
Sale price
Rs. 589.00
Unit price
/
per
Tax included.
Couldn't load pickup availability
- Semi-Micro Spatula - with one end rounded and other end tapered
- Stainless steel, rust & corrosion free
- Overall length - 20 cm. Wire Dia. - 4 mm.
- Export quality high grade semi-micro spatula
-
Pack of 5
Share